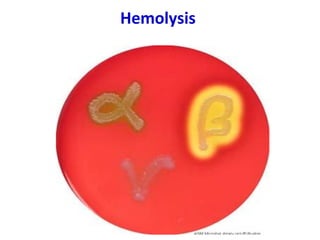
Hemolysis
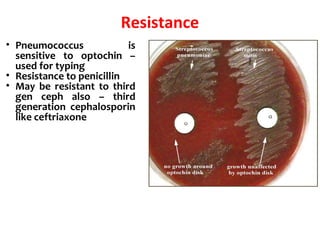
Resistance
• Pneumococcus is
sensitive to optochin –
used for typing
• Resistance to penicillin
• May be resistant to third
gen ceph also – third
generation cephalosporin
like ceftriaxone

Streptococcus is a genus of bacteria that appears in chains or pairs of spherical cocci. They are classified into groups A-V based on cell wall carbohydrates. S. pyogenes of group A is an important human pathogen. It produces toxins like streptolysins and erythrogenic toxin. Enzymes such as streptokinase and hyaluronidase aid its invasion and spread. S. pyogenes is identified by beta-hemolysis on blood agar and positive PYR test.

![Streptococcal Diseases
Suppurative Complications
1. Respiratory infections
Primary site of invasion is throat causing SORE THROAT
May be localized as tonsillitis or pharyngitis
Lipoteichoic acid covering surface pili binds to the glycoprotein
fibronectin on epithelial cells of pharynx
From the throat, spreads to surrounding tissues leading to suppurative
complications like
Otitis media
Mastoiditis
Quinsy
Suppurative adenitis
Meningitis (rare)
(it is an inflammation of the mucosal lining of the mastoid antrum and mastoid air cell system
inside[1]
the mastoid process. The mastoid process is the portion of the temporal bone of the skull
that is behind the ear which contains open, air-containing spaces.
(Peritonsillar abscess (PTA), also known as a quinsy, is pus due to an infection behind the
tonsil).
Adenitis is a general term for an inflammation of a gland
tonsillitis pharyngitispharyngitis](https://image.slidesharecdn.com/genusstreptococcus-190604025329/85/Genus-Streptococcus-29-320.jpg)